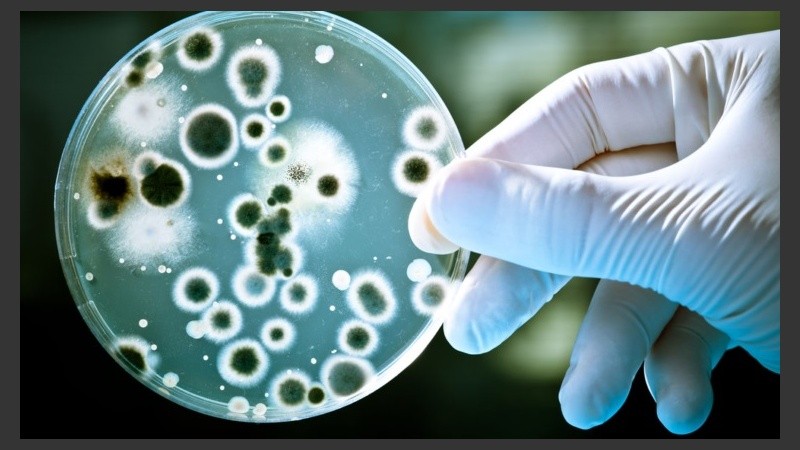
la labor del infectólogo en la institución hospitalaria apunta no sólo a cuidar la flora hospitalaria sino asesorar en cómo enfrentar a las infecciones.

Hoy, en el mundo, el uso indiscriminado de antibióticos, entre otros motivos del que no escapa la automedicación, la resistencia bacteriana a los antibióticos ha pasado a ser un tema que exige atención, dedicación, cambio de hábitos y conductas apropiadas de parte de toda la sociedad.
Hospitales, sanatorios y clínicas médicas donde se practican actos quirúrgicos y se internan pacientes disponen de un departamento de infectología para detectar y controlar los agentes microbianos existentes en esas instituciones.
“Es fundamental en estas épocas”, sostiene Mirta Castelli, médica infectóloga y Coordinadora del Departamento de Vacunas de IPAM, centro médico. “El control incluye limpieza, control de la asepsia, manejo de los restos biológicos e instrumental, control de la permanencia de los pacientes en el nosocomio, focalizando en las altas precoces de los pacientes; justamente para evitar infecciones intrahospitalarias que puede transformarse en un problema adicional al que ya tiene el paciente. Esas infecciones son un verdadero desafío para el equipo de salud”, sostiene Castelli.
Hoy se habla de las superbacterias, ¿son tan "súper" o nosotros estamos más vulnerables?
Estas superbacterias pueden estar en la comunidad; la pueden portar pacientes crónicos, debilitados y medicados con múltiples antibióticos; pero, generalmente estas super bacterias resistentes son intrahospitalarias. Hay pacientes que por razones del proceso de su enfermedad deben estar más tiemp. internados; pacientes con diferentes tipos de antibióticos etc. Y esto hace que la flora se vaya seleccionando y aparecen estas bacterias multiresistentes. Para muchas de las cuales no se dispone de antibióticos para inhibirlas; o los que existen ya no tienen la efectividad que antes tenían.
¿En esto tiene que ver el uso indiscriminado de antibióticos?
Obviamente que sí. A esto debemos agregar que el médico por inseguridad o por temor a ser demandado, ante la menor duda y sin corroboración de laboratorio bioquímico, se cubre con la prescripción de un antibiótico de amplio espectro; y esto ayuda a la formación de bacterias multirresistentes.
Por eso la labor del infectólogo en la institución hospitalaria apunta no sólo a cuidar la flora hospitalaria sino asesorar al cuerpo de profesionales de la salud en cómo enfrentar a las infecciones.
Cuando tenemos un paciente internado y hace un cuadro febril; nosotros le hacemos todos los estudios y enviamos al laboratorio de microbiología las muestras para que informen los antibióticos apropiados; mientras tanto al paciente se lo medica con el antibiótico que en ese momento se está usando para inhibir la flora hospitalaria. Debemos hacer un seguimiento continuo y estar enterados de la composición de la flora hospitalaria.
Lo que incumbe al ámbito hospitalario ustedes lo conocen por los registros cotidianos que hacen; ¿cómo enfrentan a las infecciones que los pacientes traen de la comunidad?
Nosotros podemos saber qué flora trae el paciente de la comunidad; por ejemplo, si el paciente consulta por una complicación respiratoria que toma nariz garganta y bronquios decimos que es un virus; el 80% de las infecciones respiratorias de la comunidad son producidas por virus. En éstas no se le indica antibióticos. Pero si el paciente viene con una neumonía de la comunidad, nosotros tenemos antibióticos para usar; ya que las mismas son a neumococo; es decir, una bacteria común. Pero si viene con una infección de piel y partes blandas, como la forunculosis recurrente que es una enfermedad habitual en la comunidad, la que ya se ha vuelto resistente en la comunidad; entonces no podemos empezar con los antibióticos comunes y que se usan en este momento; tenemos que recurrir a antobióticos ya en desuso que se muestran efectivos frente al estafilococo resistente de la comunidad.
¿Quiere decir que un antibiótico que entró en desuso se vuelve efectivo?
La mayoría de las veces ese razonamiento es exacto. ¿Qué hacemos? Por ejemplo en infecciones urinarias sin síntomas muy frecuentes en las mujeres; y, también en el hombre cuando comienza con los trastornos prostáticos, recurrimos a antibióticos que con el tiempo debimos dejar de medicar porque no tenían efectos terapéuticos. Hoy, luego del desuso, volvemos a indicarlos con éxito.
Estas infecciones comienzan a ser tratadas empíricamente mientras esperamos el informe del análisis bacteriológico. En el que vienen informados antibióticos que se habían vuelto inefectivos, a los que hoy podemos volver a usar, ya que al no prescribirlos por inefectivos, después de un tiempo se volvieron sensibles.

Infectóloga Coordinadora del Vacunatorio del Centro Médico IPAM